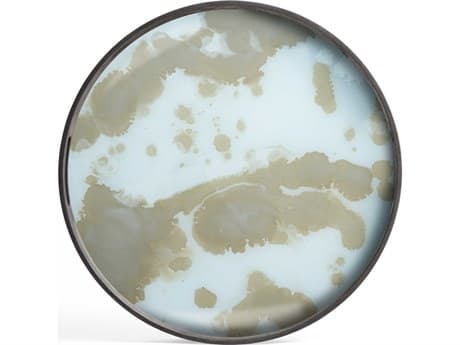
Organic

Built around a philosophy of quiet beauty and lasting connection, Ethnicraft has sought to honor the soulful character of wood, transforming it into pieces that feel as natural in a home as the stories they eventually hold. Each design is stripped of excess, revealing clean lines, soft edges, and honest materials that invite touch and time. There’s no pretense here, just thoughtful craftsmanship and the kind of simplicity that deepens with age.
Ethnicraft’s furniture doesn’t demand attention; it earns it through presence. Dining tables become gathering grounds. Shelving transforms into personal altars. Desks anchor daily rhythms, and seating offers quiet refuge. These are pieces designed not only to be lived with, but to be lived in—growing richer, more familiar, more loved with every passing year.
At the heart of it all is a deep respect for material, process, and planet. Ethnicraft sources its wood from responsibly managed forests, applies non-toxic finishes that highlight the grain rather than mask it, and repurposes off-cuts to minimize waste. The entire philosophy centers on longevity—furniture made to last, to be repaired, to be passed on. Even their approach to consumption reflects care, encouraging mindful living and intentional design choices.
Ethnicraft believes that furniture should do more than just fill a room, it should ground it in meaning. There’s poetry in the way their pieces age, how they absorb the texture of life without ever losing their own. In a world of disposable trends, Ethnicraft offers a quiet kind of permanence in luxury. Ethnicraft embodies the comfort of something built not just to be seen, but to be lived in, every single day.